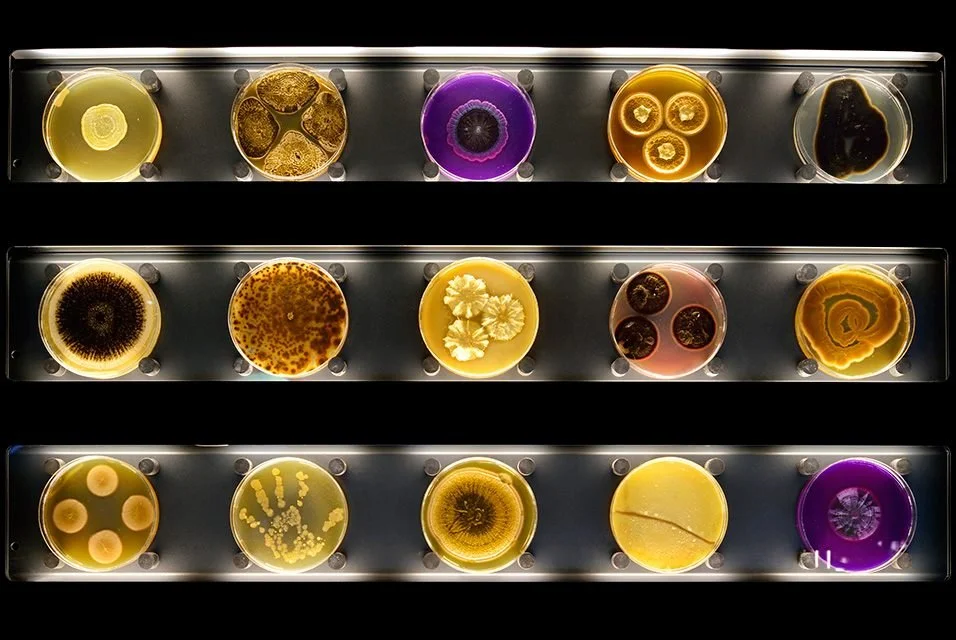

The future enters into us, in order to transform itself in us, long before it happens.
Rainer Maria Rilke



To reconnect with the living, we need to broaden our listening, to hear the world rustle with signs and ideas everywhere, to reopen the landscape of meaning - to hear the ideas of water, the phrases of animals, the thoughts of trees and forests.
Marielle Macé

The octopus represents this animal and physical connection that we have lost. (...) To the image of the octopus, which has its brain in its tentacles, I sincerely believe that it is possible to think by feeling.
Laure Provost

THE GREAT ANIMAL ORCHESTRA
The Fondation Cartier invited United Visual Artists to collaborate on The Great Animal Orchestra, the 2016 exhibition that celebrates the work of musician, bio-acoustician and scientist Bernie Krause. Krause has been recording animals for 45 years and has amassed a collection of more than 5,000 hours of sounds recordings of over 15,000 individual species in their natural habitats from all over the world. The spectrograms form an abstract landscape, an interpretation of the various global locations and times of day that Krause made the original recordings in a way that envelops the audience and encourages them to linger in the space.
Inspired in partly by the work of Bernie Krauze, Richard Barrett composed the extraordinary ten-movement cycle ‘life-form’ for cello and surround fixed electronics.
The role of the musician must be this fundamental research: to find answers to phenomena we don't understand, and to enlarge our powers of conception and action. So it is perpetual exploration.
Iannis Xenakis

The world is multidimensional in its essence. Mental processes are also multidimensional. Why not demand that models of musical thinking be multidimensional?
Leon Theremin




The landscape is magic.
The trip is far from being over.
CARLO ROVELLI